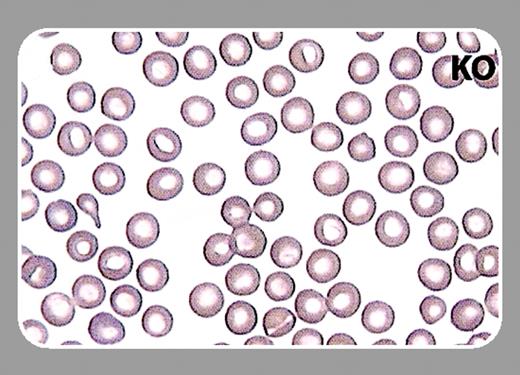
graphic

Multicellular organisms have developed complex organ systems for the uptake, transport, and delivery of oxygen. Many processes involved in oxygen homeostasis are mediated by hypoxia-inducible factors (HIFs), which control the transcription of a number of target genes. Initially identified as the key regulators of the erythropoietin gene, HIFs have subsequently been shown to participate in the control of a wide array of oxygen-regulated genes.FIG1
The HIF transcriptional complex is a heterodimer consisting of an alpha subunit (HIF-1α, HIF-2α, or HIF-3α) and a beta subunit called ARNT (arylhydrocarbon receptor nuclear translocator). During hypoxia the HIF complex up-regulates the expression of a number of genes involved in erythropoiesis, angiogenesis, vasomotor control, and energy metabolism by binding to a hypoxia-response element in target genes. The regulation of HIF-complex activity is primarily at the level of HIF alpha subunit protein stability. While the ARNT subunit is not affected by hypoxia, HIF-1α and HIF-2α proteins accumulate under hypoxic conditions and are rapidly degraded under normoxic conditions. The cellular oxygen sensor underlying this regulation resides in a number of prolyl hydroxylase enzymes (designated PHDs) which, under normoxic conditions, hydroxylate critical residues on the HIF-α subunit. These modifications serve as signals for binding to the von Hippel-Lindau (VHL) protein that facilitates HIF-α ubiquitination and subsequent degradation via the proteosome pathway.
What then do the HIFs have to do with hematopoiesis? Previous studies showed that hypoxia induces a significant increase in colony-forming units (CFUs) derived from human bone marrow (see Maeda et al, Exp Hematol. 1986;14:930-934). More recently, Adelman et al (Genes & Dev. 1999;13: 2478-2483) showed that wild-type but not ARNT null embryoid bodies showed increased CFUs in response to hypoxia. In addition, they found that ARNT null embryos had decreased numbers of yolk sac hematopoietic progenitors. To determine whether this defect was intrinsic to hematopoietic progenitors, Adelman and colleagues generated chimeric mice by injecting wild-type or ARNT null embryonic stem (ES) cells into normal blastocysts and assaying CFU formation in adult marrow. As in the wild-type control, the number of ARNT null CFUs correlated with the percent chimerism of each animal, indicating a defect extrinsic to the hematopoietic progenitors. ARNT null embryoid bodies had a markedly decreased production of vascular endothelial growth factor (VEGF) when cultured in hypoxic conditions. Addition of exogenous VEGF to ARNT null embryoid bodies restored CFU numbers to normal. Together, these studies suggested that embryonic hematopoiesis requires hypoxic ARNT activity and that physiologic hypoxia encountered by embryos is essential for the proliferation or survival of hematopoietic precursors during development. These studies did not determine whether HIF-1α or HIF-2α were necessary for this ARNT activity.
In the current issue, Scortegagna and colleagues (page 1634) have shown that HIF-2α (also known as endothelial PAS domain protein 1 [EPAS1]) is essential for normal hematopoiesis in mice. They generated viable adult EPAS1/HIF-2α null mice that were pancytopenic with hypocellular marrows. Multilineage hematopoietic maturation was normal but quantitatively reduced. Bone marrow from EPAS1/HIF-2α null mice functioned normally when transplanted into irradiated wild-type recipients. In contrast, transplantation of wild-type marrow into irradiated EPAS1/HIF-2α null recipients resulted in impaired hematopoietic reconstitution, indicating a defect in the marrow microenvironment. Interestingly, levels of VEGF and VEGF receptor mRNA in marrow from EPAS1/HIF-2α null mice did not differ from that of wild-type mice. On the other hand, expression of mRNA for a number of cell surface proteins, including vascular cell adhesion molecule 1 (VCAM-1), urokinase-type plasminogen activator receptor (uPAR), and fibronectin, were substantially altered in marrow from EPAS1/HIF-2α null mice. These studies reinforce both the importance of the HIF transcriptional complex in hematopoiesis and its function in providing the necessary marrow microenvironment for effective hematopoiesis. The different role of VEGF in embryonic and adult hematopoiesis is puzzling and may relate to a greater degree of hypoxia found in the embryonic hematopoietic compartment or be intrinsic to embryonic versus adult hematopoietic progenitors. Additional studies will be required to define whether EPAS1/HIF-2α is the ARNT partner required for embryonic as well as adult hematopoiesis. This study provides important insights into marrow stromal cell biology and opens potential avenues of exploration both into the role of stroma in marrow failure syndromes and into novel ways to support and expand hematopoietic progenitors in vitro.
This feature is available to Subscribers Only
Sign In or Create an Account Close Modal